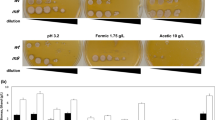

Abstract
In the industrial production of bioethanol from lignocellulosic biomass, a strain of Saccharomyces cerevisiae that can ferment xylose in the presence of inhibitors is of utmost importance. The recombinant, industrial-flocculating S. cerevisiae strain NAPX37, which can ferment xylose, was used as the parent to delete the gene encoding p-nitrophenylphosphatase (PHO13) and overexpress the gene encoding transaldolase (TAL1) to evaluate the synergistic effects of these two genes on xylose fermentation in the presence of weak acid inhibitors, including formic, acetic, or levulinic acids. TAL1 over-expression or PHO13 deletion improved xylose fermentation as well as the tolerance of NAPX37 to all three weak acids. The simultaneous deletion of PHO13 and the over-expression of TAL1 had synergistic effects and improved ethanol production and reduction of xylitol accumulation in the absence and presence of weak acid inhibitors.
Similar content being viewed by others
Avoid common mistakes on your manuscript.
Introduction
There is interest in the application of renewable resources, such as lignocellulosic biomass, for the production of bioethanol, the cleanest liquid fuel alternative to fossil fuels. Lignocellulosic biomass, such as energy crops, wood, and agricultural residues, primarily consist of cellulose, hemicelluloses, and lignin (Matsushika et al. 2009a; Kim et al. 2013). Lignocellulosic biomass is the most abundant, renewable carbohydrate source for bioethanol production and does not compete with food supplies (Matsushika et al. 2009a; Ismail et al. 2013). Xylose is the second most abundant monosaccharide present in the hydrolysate of lignocellulosic biomass and should be fermented to ethanol to develop an economically feasible process of lignocellulosic bioethanol production (Van Vleet et al. 2008; Matsushika et al. 2012).
Saccharomyces cerevisiae, amongst numerous fermentative microorganisms, is an industrial producer of ethanol due to its physiology and tolerance to ethanol (Van Vleet et al. 2008). Unfortunately, S. cerevisiae cannot utilize pentoses, especially d-xylose, to produce ethanol. Furthermore, some inhibitors are inevitably present in the hydrolysate of lignocellulosic biomass and have negative effects on the growth and fermentation of yeast strains during bioethanol production. Therefore, extensive researches had been performed to engineer S. cerevisiae strains with the ability to metabolize xylose and tolerate inhibitors. Although significant progress has been made (Van Vleet and Jeffries 2009; Almeida et al. 2011; Jönsson et al. 2013), more research still needs to be conducted on the industrial production of cellulosic ethanol.
Although S. cerevisiae is unable to metabolize xylose, it has the metabolic pathway to convert xylulose, a keto-isomer of d-xylose, into ethanol. Xylulose can be phosphorylated to xylulose 5-phosphate by xylulokinase (XK) and degraded via the pentose phosphate pathway then channeled into glycolysis. Numerous studies have been conducted to link extracellular xylose with intracellular xylulose to further improve the efficiency of xylose fermentation (Matsushika et al. 2009a). One key advancement made in these genetic engineering studies was the heterologous expression of xylose reductase (XR) and xylitol dehydrogenase (XDH) from Scheffersomyces (Pichia) stipities, along with over-expression of XK. In this pathway, XR reduces xylose to xylitol, which is then oxidized to xylulose by XDH (Fujitomi et al. 2012; Kato et al. 2012). However, the fermentation rates and ethanol yields from lignocellulosic hydrolysate by these engineered S. cerevisiae strains are still limited by the toxic compounds generated during the pretreatment process (Hasunuma et al. 2011; Sanda et al. 2011; Fujitomi et al. 2012). These toxic compounds are divided into three main groups based on origin: weak acids, furan derivatives, and phenolic compounds (Palmqvist and Hahn-Hägerdal 2000a, b). These toxins negatively affect cell growth, metabolism, and ethanol production.
The most common weak acids present in lignocellulosic hydrolysates include acetic, formic, and levulinic acids. Acetic acid is produced by the de-acetylation of hemicellulose and typically found at a higher concentration than those of other weak acids. Formic acid could be formed by the breakdown of 5-hydroxymethyl-2-furaldehyde (HMF) and furfural decomposition under acidic conditions at high temperatures (Larsson et al. 1999; Liu et al. 2012). The concentration of formic acid is typically lower than that of acetic acid but formic acid is more toxic to S. cerevisiae than acetic acid (Hasunuma et al. 2011). Levulinic acid is present at even lower concentrations than formic acid but it may be a more potent inhibitor than acetic acid due to its lower pKa value and higher lipophilicity (Larsson et al. 1999; Almeida et al. 2007; Jönsson et al. 2013). The concentrations of these weak acids in lignocellulosic hydrolysates depend on the type of biomass, pretreatment, and hydrolysis methods (Larsson et al. 1999; Palmqvist and Hahn-Hägerdal 2000b; Almeida et al. 2007; Sánchez and Cardona 2008; Liu et al. 2012).
Low concentrations of weak acids can increase the ethanol yield but high concentrations of these acids inhibit ethanol production (Larsson et al. 1999; Palmqvist et al. 1999). Based on these observations, there are two proposed mechanisms of inhibition of weak acids: uncoupling and intracellular anion accumulation (Palmqvist and Hahn-Hägerdal 2000b; Almeida et al. 2007). The undissociated form of weak acids can diffuse from the fermentation medium across the plasma membrane and dissociate due to a higher intracellular pH, decreasing the cytosolic pH. In addition, weak acids can also inhibit yeast growth by reducing the uptake of aromatic amino acids from the medium, most likely due to the strong inhibition of the Tat2p amino acid permease (Almeida et al. 2007).
To improve the inhibitor tolerance of the strain during the fermentation, metabolic, genetic and evolutionary engineering strategies have been used (Almeida et al. 2007). Deleting the gene encoding p-nitrophenyl phosphatase (PHO13) in recombinant S. cerevisiae strains may improve growth and ethanol production from xylose in both the presence and absence of inhibitors (Van Vleet et al. 2008; Fujitomi et al. 2012). The TAL1 gene, encoding transaldolase that converts sedoheptulose 7-phosphate and glyceraldehyde 3-phosphate to erythrose 4-phosphate and fructose 6-phosphate, had also been studied; its over-expression again can improve the efficiency of xylose fermentation and inhibitor tolerance (Walfridsson et al. 1995; Ni et al. 2007; Bengtsson et al. 2008; Hasunuma et al. 2011).
Although genetic engineering strategies have been useful in improving the resistance of S. cerevisiae strains to inhibitors, most studies use laboratory strains as starting strains and it is unclear whether the results of these studies are applicable to industrial strains. For industrial bioethanol production, selecting industrial yeast strains is very important for optimal performance under industrial conditions (Matsushika et al. 2009a, b). Many industrial strains exhibit increased tolerance to inhibitors in lignocellulosic hydrolysates compared to that of laboratory strains. In the present study, a recombinant flocculating industrial S. cerevisiae strain that could ferment xylose was selected as parental strain to evaluate the effects of PHO13 deletion and TAL1 over-expression on ethanol production in the presence of weak acid inhibitors, including formic, acetic, and levulinic acids. Most importantly, the synergistic effects of these two genes on xylose fermentation were investigated.
Materials and methods
Strains, plasmids, and primers
The xylose-utilizing recombinant industrial S. cerevisiae strain NAPX37 was genetically engineered from the industrial flocculent yeast strain KF-7 (Tang et al. 2006) by genome-integrating XYL1, XYL2, and GXS1 from Scheffersomyces stipitis as well as BGL1 from Saccharomycopsis fibuligera and over-expressing S. cerevisiae XKS1 and HXT7, so the strain can metabolize xylose and cellobiose (Liu et al. 2012). The plasmids pBlu-LTKTL-TDH3 and pZeo were developed in a previous study (Tomitaka et al. 2013). Escherichia coli DH5α were used for plasmid preparations. The yeast strains, plasmids, and primers used in the present study are summarized in Supplementary Tables S1 and S2.
Medium
Yeast strains were routinely cultivated at 30 °C in 2 % YPD medium (20 g peptone/l, 10 g yeast extract/l, and 20 g glucose/l) with 1.5 % (w/v) agar. Each strain was cultured in spore medium (0.5 g glucose/l, 20 g potassium acetate/l, 2 g yeast extract/l, pH 5.5) for spore formation. Strains harboring the plasmid pZeo were grown on YPD/Zeo medium (2 % YPD medium containing 100 mg zeocin/l). YPG medium (20 g peptone/l, 10 g yeast extract/l, and 20 g galactose/l) was used to induce the expression of Cre recombinase from the pZeo plasmid. Batch fermentation was performed in 4 % YPX medium (20 g peptone/l, 10 g yeast extract/l, and 40 g xylose/l). E. coli was grown in LB medium (10 g peptone/l, 5 g yeast extract/l, and 5 g NaCl/l) containing 100 mg ampicillin/l.
Generation of haploid strain
Diploid strains were cultured in spore medium for 2–3 days, and then the tetrad was dissected using Singer MSM300 System (Singer Instruments, UK) after treated with lyticase (1 U/μl) at 30 °C for 20 min. Spores were cultured in 2 % YPD medium containing 40 mg adenine sulfate/l at 30 °C for 2–3 days, and the ploidy of cells was determined by microscope observation and spore forming test. Finally, the mating types of the cells were determined by their abilities to mate with haploid strains NAM26-15A (MATa) and NAM34-4C (MATα).
Construction of yeast strains
Fusion PCR was used to amplify the PHO13 deletion cassette with kanMX as the marker. The loxP-P TEF -kanMX-T TEF -loxP fragment was amplified from the plasmid pBlu-LTKTL-TDH3 using the primers Fout and Rout, and the upstream fragment of the PHO13 gene was amplified from the yeast genome using the primers F1 and R. The fragment for transformation (2342 bp) was amplified by fusion PCR using the primers F1 and Rout. Transformations were performed using the lithium acetate method as described previously (Tomitaka et al. 2013). The fusion fragments were transformed to the PHO13 gene region of haploid strains NAPX37-a and NAPX37-α for homologous recombination to yield PHO13 deleted strains NAPX37/ΔPHO13-a and NAPX37/ΔPHO13-α, respectively. Mating these two haploid strains to generate the diploid strain NAPX37/ΔPHO13.
The loxP-P TEF -kanMX-T TEF -loxP-P TDH3 fragment was amplified from the plasmid pBlu-LTKTL-TDH3 using the primers TAL1-loxP and TAL1-TDH3p harboring the sequences for homologous recombination of TAL1 promoter. The fragments were transformed to the promoter region of TAL1 gene of haploid strains NAPX37-a and NAPX37-α for homologous recombination to produce the TAL1 over-expressing strains NAPX37/TAL1-a and NAPX37/TAL1-α, respectively. The transformation was confirmed by PCR using the primers F-TAL1-UP800 and R-TAL1-DOWN200, and two haploid strains were mated to produce the diploid strain NAPX37/TAL1.
PHO13 deleted strains NAPX37/ΔPHO13-a and NAPX37/ΔPHO13-α were used as parental strains for generating strains with PHO13 deletion and TAL1 over-expression. The kanMX marker was firstly removed from NAPX37/ΔPHO13-a and NAPX37/ΔPHO13-α strains using the methods described by Tomitaka et al. (2013). Briefly, the strain containing the loxP-kanMX-loxP cassette was transformed with plasmid pZeo harboring the cre gene. The expression of Cre recombinase was induced by galactose in YPG medium, and then the kanMX marker was knocked out. The loxP-P TEF -kanMX-T TEF -loxP-P TDH3 was amplified from the genome of NAPX37/TAL1 using the primers Ftal and Rtal. The fragments were transformed to the promoter region of TAL1 gene of haploid strains NAPX37/ΔPHO13-a and NAPX37/ΔPHO13-αfor homologous recombination to produce TAL1 over-expressing strains NAPX37/ΔPHO13-TAL1-a and NAPX37/ΔPHO13-TAL1-α, respectively. The transformation was also confirmed by PCR using the primers F-TAL1-UP800 and R-TAL1-DOWN200, and two haploid strains were mated to produce the diploid strain NAPX37/ΔPHO13-TAL1.
Aerobic growth kinetics
After pre-cultivation in 2 % YPD medium for 16 h, yeast cells were harvested by centrifugation at 3,000g at 4 °C for 6 min. The cell pellets were then washed twice with distilled water and used to inoculate 2 % YPX medium. The initial cell concentration was adjusted to an OD660 value of 0.05, and aerobic cultivation was performed at 30 °C with shaking at 160 rpm in a 500 ml flask. Cultivation broth was sampled periodically (2 ml) and centrifuged at 9,000g for 3 min. Cell pellet was washed twice with distilled water and then dispersed in 0.05 mM EDTA to measure the OD660.
Fermentation assays with inhibitors
After pre-cultivation in 2 % YPD agar plate for 24 h, yeast cells were cultured under aerobic conditions at 30 °C for 16 h in 5 % YPD medium. Cells were harvested by centrifugation at 3,000g at 4 °C for 6 min, and washed twice with distilled water. Cell pellet was inoculated to 4 % YPX fermentation medium containing the inhibitors, formic acid, acetic acid, or levulinic acid. The initial cell concentration was adjusted to 50 g wet cell/l (10 g/l dry cell weight), and the fermentation was performed at 35 °C for 48 h with an agitation speed of 200 rpm in a 300 ml flask. The agitation speed was controlled by a HS-6DN magnetic stirrer (As One, Japan).
Measurement of fermentation products
Xylose in the fermentation medium was determined by a HPLC equipped with a fluorescence detector (RF-10AXL) as previously described (Tang et al. 2006). Ethanol was measured by GC with an FID detector. 2-propanol was used as the internal standard (Tang et al. 2006). Xylitol and glycerol were assayed by HPLC equipped with an Aminex HPX-87H column (300 × 7.8 mm) (Bio-Rad, USA) and a refractive index detector. The HPLC was operated at 65 °C, with a mobile phase of 5 mM H2SO4, at 0.6 ml/min with an injection of 50 μl.
Results and discussion
Aerobic growth kinetics
The diploid strains, NAPX37/ΔPHO13, NAPX37/TAL1, and NAPX37/ΔPHO13-TAL1 (Supplementary Table S1) constructed using strain NAPX37 as the parental strain. The growth of the parental and engineered strains in 2 % YPX medium under aerobic conditions were investigated (Fig. 1). Although the growth of the parental strain NAPX37 was slower than that of the other three strains, the difference was not significant. Strain NAPX37/ΔPHO13-TAL1 entered the stationary phase first. The times of the growth phases for NAPX37/ΔPHO13 and NAPX37/TAL1 were almost identical, but the biomass of the latter was higher. However, the biomass of both of them were greater than that of the parental strain NAPX37. These results indicate that PHO13 deletion or TAL1 over-expression has positive effects on cell growth, which is in accordance with previous studies, but the effects were not as significant compared to those of previous studies (Walfridsson et al. 1995; Ni et al. 2007; Van Vleet et al. 2008; Fujitomi et al. 2012). The differences in genetic background of these strains could explain the different effects of PHO13 deletion or TAL1 over-expression. The parental strain NAPX37 exhibits good growth characteristics when cultivated in medium with xylose as its sole carbon source.
Aerobic growth kinetics of the engineered strains. The initial cell concentration was adjusted to an OD660 of 0.05. Symbols NAPX37 (circles), NAPX37/ΔPHO13 (triangles), NAPX37/TAL1 (diamonds), and NAPX37/ΔPHO13-TAL1 (squares). Values represent the averages of duplicate experiments, and the standard deviations (SD) were <5 % of the mean
Xylose fermentation in the absence of inhibitors
The xylose fermentation ability of the four diploid strains NAPX37, NAPX37/ΔPHO13, NAPX37/TAL1, and NAPX37/ΔPHO13-TAL1 under O2 limited conditions at 35 °C was evaluated. The initial cell concentration was adjusted to 10 g DCW/l. As shown in Fig. 2, the four strains nearly consumed all xylose within 12 h. NAPX37/ΔPHO13-TAL1 produced the highest amount of ethanol and exhibited a slight decrease in the accumulation of xylitol after 48 h. The maximum xylose consumption rate and specific ethanol productivity were 6.22 g xylose/g DCW/h and 1.81 g ethanol/g DCW/h, respectively (Table 1). However, they were 5.31 g xylose/g DCW h and 1.54 g ethanol/g DCW/h for the control strains NAPX37, respectively. The strains NAPX37/ΔPHO13 and NAPX37/TAL1 displayed moderate fermentation ability, but the xylose consumption rate and ethanol productivity of the former was lower than those of the latter (Table 1). Although all strains displayed low glycerol yields, the strain NAPX37/TAL1 still produced the lowest amount of glycerol (Fig. 2).
These results indicated that PHO13 deletion or TAL1 over-expression in strain NAPX37 could improve xylose consumption and ethanol production. According to previous studies, PHO13 deletion or TAL1 over-expression had good effects on ethanol production for S. cerevisiae strains (Ni et al. 2007; Van Vleet et al. 2008; Fujitomi et al. 2012; Sanda et al. 2011).
TAL1 over-expression can improve the efficiency of xylose consumption and fermentation of S. cerevisiae (Walfridsson et al. 1995; Ni et al. 2007; Bengtsson et al. 2008; Hasunuma et al. 2011). Deleting or reducing PHO13 expression in S. cerevisiae strains also enhanced the fermentation of xylose (Ni et al. 2007; Van Vleet et al. 2008; Fujitomi et al. 2012). However, the synergistic effects of these two genes on xylose fermentation are still unclear. In the present study, the simultaneous deletion of the PHO13 gene and over-expression of TAL1 gene could improve ethanol production and decrease the accumulation of xylitol of industrial S. cerevisiae.
Xylose fermentation in the presence of formic acid
Xylose fermentation in the presence of 15 and 30 mM formic acid was investigated (Fig. 3). Fermentation was significantly inhibited with an increase in the concentration of formic acid. In the presence of 15 mM formic acid, four strains exhibited good xylose fermentation capabilities. The parental strain NAPX37 produced 10.9 g ethanol/l with 33.8 g xylose consumption, whereas the strains NAPX37/ΔPHO13, NAPX37/TAL1, and NAPX37/ΔPHO13-TAL1 generated 11.3, 11.5, and 12.3 g ethanol/l, respectively (Fig. 3). In addition, the xylitol yields of NAPX37/ΔPHO13, NAPX37/TAL1, and NAPX37/ΔPHO13-TAL1 strains decreased by 29, 25, and 36 %, respectively, compared to that of the parental strain (Table 1). However, when formic acid was increased to 30 mM, only 9.22 g xylose was consumed by the parental strain NAPX37 and 1.4 g ethanol/l was produced. PHO13 deletion or TAL1 over-expression could enhance the ethanol yield slightly, and the yield was further enhanced by the simultaneous deletion and over-expression of these two genes. Strain NAPX37/ΔPHO13-TAL1 produced 2.67 g ethanol/l after 48 h fermentation, which is 1.3-, 1.5-, and 1.9-fold higher than that of NAPX37/TAL1, NAPX37/ΔPHO13, and NAPX37, respectively. These results indicate that simultaneously over-expressing TAL1 and deleting PHO13 has synergistic effects on improving the resistance of S. cerevisiae strains to formic acid during the production of ethanol from xylose.
Comparison of xylose fermentation capability of engineered strains in the presence of 15 mM (open symbols) and 30 mM (closed symbols) formic acid. The initial cell concentration was 10 g DCW/l. Symbols xylose (squares), ethanol (diamonds), xylitol (circles), and glycerol (triangles). Values represent the averages of duplicate experiments ± SD
Formic acid is the most toxic weak acid in lignocellulosic hydrolysates due to its low molecular weight and lower pKa value (Larsson et al. 1999; Almeida et al. 2007; Jönsson et al. 2013). In the present study, the initial pH of the fermentation medium may be an important factor affecting the performance of the strains, as another study in our laboratory showed that the fermentation ability of the strain NAPX37 could be significantly improved when the medium pH was adjusted to 5 even though formic acid was increased to 80 mM (data not shown). A laboratory xylose-fermenting S. cerevisiae strain over-expressing TAL1 or with the deletion of PHO13 improved ethanol yields when exposed to formic acid (Sanda et al. 2011; Fujitomi et al. 2012). The ethanol yield of strains with PHO13 deletion or TAL1 over-expression decreased slightly compared to that of the parental strain used in this study, whereas the ethanol yield of the strain over-expressing TAL1 with the PHO13 deletion improved, indicating that these two genes exhibited synergistic effects on xylose fermentation of the industrial S. cerevisiae strain in the presence of formic acid.
Xylose fermentation in the presence of acetic acid
The effects of acetic acid (30 and 60 mM) on the four engineered S. cerevisiae strains were evaluated (Fig. 4). Xylose consumption in the four strains significantly decreased with the increase of acetic acid concentration. Xylose was almost completely metabolized within 24 h in the presence of 30 mM acetic acid. However, its concentration after 48 h fermentation in the presence of 60 mM acetic acid was almost the same as that after 12 h fermentation in the presence of 30 mM acetic acid. Although the specific xylose consumption of the strain with PHO13 deletion or TAL1 over-expression was slightly different under the same conditions (Table 1), the strain NAPX37/ΔPHO13 and NAPX37/TAL1 displayed better xylose fermentation capabilities compared with that of the parental strain. The ethanol yields of these two strains at 30 mM acetic acid were 0.34 g/g xylose and 0.32 g/g xylose, respectively. At 60 mM acetic acid, the ethanol yields of NAPX37/ΔPHO13 and NAPX37/TAL1 were both 0.29 g/g xylose. The accumulation of xylitol by the strains NAPX37/ΔPHO13 and NAPX37/TAL1 was also lower than that of the parental strain but the yield of the former was less than the latter in the presence of the same concentration of acetic acid. Among all of the strains, NAPX37/ΔPHO13-TAL1 effectively consumed the most xylose and produced more ethanol, regardless of the concentration of acetic acid. The maximum specific xylose consumption rate and specific ethanol productivity of NAPX37/ΔPHO13-TAL1 were 3.3 g xylose/g DCW/h and 1.15 g ethanol/g DCW/h, respectively, at 30 mM acetate (Table 1). These values were both 1.26-fold higher than those of the parental strain NAPX37. Furthermore, when the acetic acid concentration was increased to 60 mM, these values were 1.45-fold and 1.32-fold higher, respectively (Table 1).
Comparison of xylose fermentation capability of engineered strains in the presence of 30 mM (open symbols) and 60 mM (closed symbols) acetic acid. The initial cell concentration was 10 g DCW/l. Symbols xylose (squares), ethanol (diamonds), xylitol (circles), and glycerol (triangles). Values represent the averages of duplicate experiments ± SD
Acetic acid is the most prominent weak acid in lignocellulosic hydrolysates and has a significant effect on xylose fermentation of S. cerevisiae strain (Almeida et al. 2007). Both TAL1 over-expression and PHO13 deletion can effectively improve the tolerance of S. cerevisiae strains to acetic acid (Hasunuma et al. 2011; Fujitomi et al. 2012). Our results are consistent with these findings, with the exception that this improvement is not significant (Table 1). Although Fujitomi et al. (2012) reported that the ethanol yield of a PHO13-deleted strain was slightly higher than that of a TAL1-over-expressing strain, our findings indicate that TAL1 over-expression seems to be conducive to producing more ethanol. These differences may be caused by the different genetic backgrounds of the strains used in each study. The parental strain NAPX37 used in this study originated from an industrial strain and has resistant to inhibitors during the fermentation of lignocellulosic hydrolysates (Liu et al. 2012). Furthermore, our results also indicated that the simultaneous over-expression of TAL1 and deletion of PHO13 exhibited synergistic effects on xylose fermentation for industrial S. cerevisiae strains in the presence of acetic acid.
Xylose fermentation in the presence of levulinic acid
Xylose fermentation in the presence of 15 and 30 mM levulinic acid was investigated (Fig. 5). In the presence of 15 mM levulinic acid, all strains consumed xylose almost completely after 24 h. The parental strain NAPX37 produced 11.8 g ethanol/l and 14 g xylitol/l, respectively (Fig. 5), whereas NAPX37/ΔPHO13 and NAPX37/TAL1 had higher yields of ethanol and lower yields of xylitol (Table 1). This trend was further enhanced by the strain NAPX37/ΔPHO13-TAL1, which produced 1.1-fold more ethanol and accumulated 81 % xylitol, compared to that of the parental strain. However, when levulinic acid was increased to 30 mM, the consumption of xylose by the four strains decreased. However, only a few grams of xylose were not consumed after 48 h (Fig. 5). Strain NAPX37 produced 10.6 g ethanol/l, and the ethanol yield of NAPX37/ΔPHO13-TAL1 increased to 0.32 g/g xylose compared to 0.29 g/g xylose of NAPX37. In addition, NAPX37 accumulated 9.26 g xylitol/l after 48 h fermentation, whereas the xylitol yields of NAPX37/ΔPHO13, NAPX37/TAL1, and NAPX37/ΔPHO13-TAL1 decreased 20, 18, and 27 %, respectively. Additionally, all strains displayed poor glycerol production but the TAL1-over-expressing strain produced the lowest amount of glycerol.
Comparison of xylose fermentation capability of engineered strains in the presence of 15 mM (open symbols) and 30 mM (closed symbols) levulinic acid. The initial cell concentration was 10 g DCW/l. Symbols xylose (squares), ethanol (diamonds), xylitol (circles), and glycerol (triangles). Values represent the averages of duplicate experiments ± SD
Levulinic acid is formed by the degradation of 5-HMF during lignocellulosic hydrolysis, and its concentration is related to the method of biomass hydrolysis (Liu et al. 2012). Few studies have investigated the effect of this inhibitor on xylose fermentation by industrial S. cerevisiae strains. Levulinic acid is a stronger inhibitor than acetic acid which may be due to its lower pKa values and higher lipophilicity (Larsson et al. 1999; Almeida et al. 2007; Jönsson et al. 2013). Here, we found that xylose consumption by strain NAPX37 after 12 h fermentation in the presence of 30 mM acetic acid is almost the same as its consumption after 24 h fermentation in the presence of 30 mM levulinic acid. However, ethanol produced in 30 mM acetic acid was 1.3-fold higher than ethanol in the same concentration of levulinic acid. Furthermore, our results also suggested that TAL1 over-expression and PHO13 deletion exhibited synergistic effects which leading to improved ethanol production during xylose fermentation of industrial S. cerevisiae strains in the presence of levulinic acid.
Conclusions
Either TAL1 over-expression or PHO13 deletion in the industrial-flocculating S. cerevisiae strain NAPX37 could improve cell growth and promote xylose consumption, which increasing the ethanol production in the absence of weak acids. In the presence of formic, acetic, or levulinic acids, the engineered strains produced more ethanol and accumulated less xylitol. The results also indicated that inhibition by levulinic acid is stronger than that of acetic acid but weaker than that of formic acid. The inhibition of weak acids also enhanced with the increase of inhibitor concentration. Most importantly, this study demonstrates that the simultaneous over-expression of TAL1 and deletion of PHO13 had synergistic effects on xylose fermentation of industrial S. cerevisiae strain in the presence of weak acids. However, further researches on the tolerance of other inhibitors including furans and aldehydes should be conducted to make the strain able to ferment lignocellulosic hydrosates with high contents of various inhibitors.
References
Almeida JRM, Modig T, Petersson A, Hahn-Hägerdal B, Liden G, Gorwa-Grauslund MF (2007) Increased tolerance and conversion of inhibitors in lignocellulosic hydrolysates by Saccharomyces cerevisiae. J Chem Technol Biotechnol 82:340–349
Almeida JR, Runquist D, Sànchezi Nogué V, Lidén G, Gorwa-Grauslund MF (2011) Stress-related challenges in pentose fermentation to ethanol by the yeast Saccharomyces cerevisiae. Biotechnol J 6:286–299
Bengtsson O, Jeppsson M, Sonderegger M, Parachin NS, Sauer U, Hahn-Hägerdal B, Gorwa-Grauslund MF (2008) Identification of common traits in improved xylose-growing Saccharomyces cerevisiae for inverse metabolic engineering. Yeast 25:835–847
Fujitomi K, Sanda T, Hasunuma T, Kondo A (2012) Deletion of the PHO13 gene in Saccharomyces cerevisiae improves ethanol production from lignocellulosic hydrolysate in the presence of acetic and formic acids, and furfural. Bioresour Technol 111:161–166
Hasunuma T, Sanda T, Yamada R, Yoshimura K, Ishii J, Kondo A (2011) Metabolic pathway engineering based on metabolomics confers acetic and formic acid tolerance to a recombinant xylose-fermenting strain of Saccharomyces cerevisiae. Microb Cell Fact 10:2
Ismail KS, Sakamoto T, Hatanaka H, Hasunuma T, Kondo A (2013) Gene expression cross-profiling in genetically modified industrial Saccharomyces cerevisiae strains during high-temperature ethanol production from xylose. J Biotechnol 163:50–60
Jönsson LJ, Alriksson B, Nilvebrant NO (2013) Bioconversion of lignocellulose: inhibitors and detoxification. Biotechnol Biofuels 6:16
Kato H, Suyama H, Yamada R, Hasunuma T, Kondo A (2012) Improvements in ethanol production from xylose by mating recombinant xylose-fermenting Saccharomyces cerevisiae strains. Appl Microbiol Biotechnol 94:1585–1592
Kim SR, Park YC, Jin YS, Seo JH (2013) Strain engineering of Saccharomyces cerevisiae for enhanced xylose metabolism. Biotechnol Adv 31:851–861
Larsson S, Palmqvist E, Hahn-Hägerdal B, Tengborg C, Stenberg K, Zacchi G, Nilvebrant NO (1999) The generation of fermentation inhibitors during dilute acid hydrolysis of softwood. Enzym Microb Technol 24:151–159
Liu ZS, Wu XL, Kida K, Tang YQ (2012) Corn stover saccharification with concentrated sulfuric acid: effects of saccharification conditions on sugar recovery and by-product generation. Bioresour Technol 119:224–233
Matsushika A, Inoue H, Kodaki T, Sawayama S (2009a) Ethanol production from xylose in engineered Saccharomyces cerevisiae strains: current state and perspectives. Appl Microbiol Biotechnol 84:37–53
Matsushika A, Inoue H, Murakami K, Takimura O, Sawayama S (2009b) Bioethanol production performance of five recombinant strains of laboratory and industrial xylose-fermenting Saccharomyces cerevisiae. Bioresour Technol 100:2392–2398
Matsushika A, Goshima T, Fujii T, Inoue H, Sawayama S, Yano S (2012) Characterization of non-oxidative transaldolase and transketolase enzymes in the pentose phosphate pathway with regard to xylose utilization by recombinant Saccharomyces cerevisiae. Enzym Microb Technol 51:16–25
Ni H, Laplaza JM, Jeffries TW (2007) Transposon mutagenesis to improve the growth of recombinant Saccharomyces cerevisiae on d-xylose. Appl Environ Microbiol 73:2061–2066
Palmqvist E, Hahn-Hägerdal B (2000a) Fermentation of lignocellulosic hydrolysates. I: inhibition and detoxification. Bioresour Technol 74:17–24
Palmqvist E, Hahn-Hägerdal B (2000b) Fermentation of lignocellulosic hydrolysates. II: inhibitors and mechanisms of inhibition. Bioresour Technol 74:25–33
Palmqvist E, Grage H, Meinander NQ, Hahn-Hägerdal B (1999) Main and interaction effects of acetic acid, furfural, and p hydroxybenzoic acid on growth and ethanol productivity of yeasts. Biotechnol Bioeng 63:46–55
Sánchez OJ, Cardona CA (2008) Trends in biotechnological production of fuel ethanol from different feedstocks. Bioresour Technol 99:5270–5295
Sanda T, Hasunuma T, Matsuda F, Kondo A (2011) Repeated-batch fermentation of lignocellulosic hydrolysate to ethanol using a hybrid Saccharomyces cerevisiae strain metabolically engineered for tolerance to acetic and formic acids. Bioresour Technol 102:7917–7924
Tang YQ, An MZ, Liu K, Nagai S, Shigematsu T, Morimura S, Kida K (2006) Ethanol production from acid hydrolysate of wood biomass using the flocculating yeast Saccharomyces cerevisiae strain KF-7. Proc Biochem 41:909–914
Tomitaka M, Taguchi H, Fukuda K, Akamatsu T, Kida K (2013) Isolation and characterization of a mutant recombinant Saccharomyces cerevisiae strain with high efficiency xylose utilization. J Biosci Bioeng 116:706–715
Van Vleet JH, Jeffries TW (2009) Yeast metabolic engineering for hemicellulosic ethanol production. Curr Opin Biotechnol 20:300–306
Van Vleet JH, Jeffries TW, Olsson L (2008) Deleting the para-nitrophenyl phosphatase (pNPPase), PHO13, in recombinant Saccharomyces cerevisiae improves growth and ethanol production on d-xylose. Metab Eng 10:360–369
Walfridsson M, Hallborn J, Penttilä M, Keränen S, Hahn-Hägerdal B (1995) Xylose-metabolizing Saccharomyces cerevisiae strains over-expressing the TKL1 and TAL1 genes encoding the pentose phosphate pathway enzymes transketolase and transaldolase. Appl Environ Microbiol 61:4184–4190
Acknowledgements
This work was supported by the National Natural Science Foundation of China (31170093).
Author information
Authors and Affiliations
Corresponding author
Electronic supplementary material
Below is the link to the electronic supplementary material.
Rights and permissions
About this article
Cite this article
Li, YC., Gou, ZX., Liu, ZS. et al. Synergistic effects of TAL1 over-expression and PHO13 deletion on the weak acid inhibition of xylose fermentation by industrial Saccharomyces cerevisiae strain. Biotechnol Lett 36, 2011–2021 (2014). https://doi.org/10.1007/s10529-014-1581-7
Received:
Accepted:
Published:
Issue Date:
DOI: https://doi.org/10.1007/s10529-014-1581-7